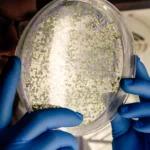
Domivita | Test na grzyby BICOM bez opisu

Domivita | Test na wirusy BICOM bez opisu
159,00 zł
Nasz innowacyjny pakiet diagnostyczny BICOM reprezentuje nowoczesne podejście do identyfikacji i rozpoznawania szerokiej gamy problemów zdrowotnych, wykorzystując zaledwie kilka kropli Twojej krwi. Skupiamy się na precyzyjnym wykrywaniu:
- Wirusów
Na stanie
⚠️ PRZED ZAKUPEM PAKIETU PROSIMY O ZAPOZNANIE SIĘ Z INFORMACJĄ
Nie prowadzimy oraz nie przyjmujemy:
• w trakcie leczenia onkologicznego / z chorobą nowotworową
• z cukrzycą typu 1
• chorujących na padaczkę / epilepsję
• będących w trakcie leczenia biologicznego
• kobiet w ciąży oraz karmiących piersią
Test na wirusy BICOM
To innowacyjne podejście do diagnostyki, które umożliwia wykrycie i identyfikację:
Wirusów: Nasze badanie pozwala na precyzyjne wykrycie różnych typów wirusów, które mogą nieść za sobą ryzyko komplikacji zdrowotnych. Dzięki wczesnemu wykryciu, możliwa jest szybka reakcja i podjęcie odpowiednich środków profilaktycznych lub terapeutycznych.
Proces badania
Po zakupie Testu na wirusy BICOM przez nasz sklep internetowy, otrzymasz zestaw do samodzielnego pobrania krwi. Należy dokładnie postępować zgodnie z instrukcją, aby pobranie było prawidłowe i aby próbka krwi mogła zostać skutecznie przeanalizowana w naszym gabinecie. Twoje zaangażowanie w ten proces jest kluczowe dla dokładności i wiarygodności wyników.
Jak to działa?
Po zakupie pakietu w naszym sklepie internetowym otrzymasz zestaw do samodzielnego pobrania krwi z opuszka palca. W zestawie znajdziesz wymazówkę, dwa nakłuwacze oraz etykietę do bezpłatnej wysyłki zwrotnej.
Wystarczy, że postąpisz zgodnie z prostą instrukcją dołączoną do zestawu:
- Wypełnij krótką ankietę zdrowotną i odeślij mailowo. (ankieta zdrowotna wysyłana automatycznie na maila, do pobrania również na koncie użytkownika)
- Pobierz próbkę krwi od osoby, która ma zostać przebadana, używając jednego z nakłuwaczy.
- Odeślij wymazówkę z krwią, korzystając z dołączonej bezpłatnej etykiety zwrotnej.
- Ankietę zdrowotną i wymazówkę odeślij w tym samym czasie.
Twoje wyniki
Wyniki badania otrzymasz bezpośrednio na swoją skrzynkę mailową w ciągu 7 dni roboczych od momentu kiedy krew trafi do naszego gabinetu.
Pakiet można odesłać w ciągu 3 miesięcy od daty zakupu. Uwaga: Etykieta zwrotna jest ważna przez 1 miesiąc od momentu jej otrzymania. Aby paczka została przyjęta bez dodatkowych kosztów, musi zostać nadana w okresie ważności etykiety. Po upływie miesiąca etykieta traci ważność, jednak nadal istnieje możliwość odesłania pakietu w ciągu 3 miesięcy od daty zakupu — w takim przypadku wysyłka odbywa się na koszt nadawcy. Zaleca się odesłanie paczki jak najszybciej po otrzymaniu etykiety, aby uniknąć dodatkowych opłat.
*Wyniki i opis w języku Polskim
| Marki | DomiVita |
|---|

O nas

Bezpiecznie i szybko
- za produkty zapłacisz dokładnie tak jak chcesz. Udostępniamy najbardziej popularne płatności online.
- Za bezpieczeństwo odpowiada Payu
- zakupione książki możesz zwrócić zgodnie z warunkami zwrotów, które znajdziesz tutaj